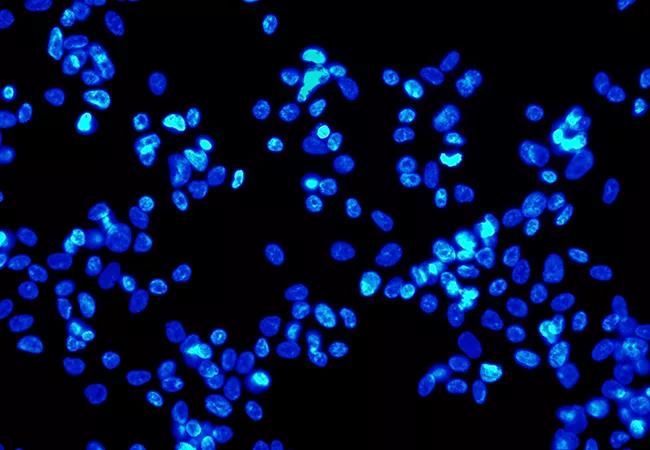

Study tests regenerative therapy
Image content: This image is available to view online.
View image online (https://assets.clevelandclinic.org/transform/da2ac4a7-63ab-4627-aa90-62801b9208e0/650x450-Stem-Cells_jpg)
650×450-Stem-Cells
By Courtenay Moore, MD
Advertisement
Cleveland Clinic is a non-profit academic medical center. Advertising on our site helps support our mission. We do not endorse non-Cleveland Clinic products or services. Policy
Urinary incontinence affects as many as 50 percent of women and can result in significant social and economic burden, with an estimated $19.5 billion spent in 2000 on the treatment of incontinence.
Stress urinary incontinence (SUI), the most common type of incontinence, is defined by the International Continence Society as “the complaint of involuntary leakage on effort or exertion, or on sneezing or coughing,” and affects as many as 35 percent of adult women.
Current treatment options for SUI include weight loss, pelvic floor physical therapy, incontinence pessaries, bulking agents and slings, all of which aim to restore normal anatomy.
Potential alternatives to these restorative therapies are regenerative therapies, which use autologous progenitor cells to regenerate the urinary sphincter.
Two phase 2 clinical studies have shown that autologous muscle-derived stem cells are safe and effective in the treatment of female SUI.
We are currently conducting and enrolling patients in a phase 3, multicenter, double-blind placebo-controlled trial investigating the safety and efficacy of using autologous muscle-derived stem cells for urinary sphincter repair in women with SUI.
Subjects undergo a quadricep femoris muscle biopsy under local anesthesia. The muscle cells are then processed and injected transurethrally into the urinary sphincter. Results will be compared with those of patients who receive a placebo injection. The primary outcome measure is the number of leaks due to stress incontinence episodes occurring during a 12-month period.
Advertisement
To be considered for inclusion, women must be ages 18 years and older with demonstrable SUI on cough stress test, Q-tip angle less than 30 degrees, body mass index less than 35 and no history of neurologic disease.
For more information regarding this study and potential patient enrollment, please contact Andrea Aaby at aabya@ccf.org or 216-444-1152.
Advertisement
Advertisement
Counseling and careful surgical considerations are key
Deprivation is linked to impaired glucose intolerance and racial disparities
Perioperative prophylaxis and class III obesity
Artesunate ointment is safe well and tolerated patients with vulvar intraepithelial neoplasia
Endoscopic balloon dilation during pregnancy helps optimize outcomes
Researchers examine waste and implore colleagues to take action
Mode of delivery does not affect patient satisfaction